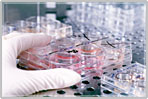
WELCOME to Excel Laboratory

![]()
In the last few years, the field of Medicine has undergone a revolution of sorts with technology, making its presence felt in almost all the facilities of clinical practice. In this rapidly changing scenario Pathology too has evolved into a highly multi-specialty field with newer techniques widening the very scope of diagnostics, making diagnosis easier and more reliable than before.
In the last few years, the field of Medicine has undergone a revolution of sorts with technology, making its presence felt in almost all the facilities of clinical practice. In this rapidly changing scenario Pathology too has evolved into a highly multi-specialty field with newer techniques widening the very scope of diagnostics, making diagnosis easier and more reliable than before.
![]()
Excel Laboratory is the center where such technology is incorporated making it one of the most advanced Diagnostic Pathology Laboratory in Mumbai.
We at Excel Laboratory are offering comprehensive pathology solutions to Clinicians & fellow Pathologists. Today we are proud to offer our range of more than 500 investigations to doctors of Mumbai and Thane and its suburbs.
![]()
E very test performed under
X cellent conditions
C onforming to
E stablished norms
L eading to better patient care
Open 24x7 including Sunday
Home visit available
Reports by E-mail & SMS
Senior citizens discounts
![]()
We have collection centers at all major hospitals at Thane and Mumbai. Some of them being ...
![]()
ABX Pentra 60
BS 200
ADVIA Centaur
VITROS DT60 II
Bio Merieux VIDAS
![]()

ISO 9001:2000
Indian Health Organization
(IHO) affiliation
NABL ( under process)


